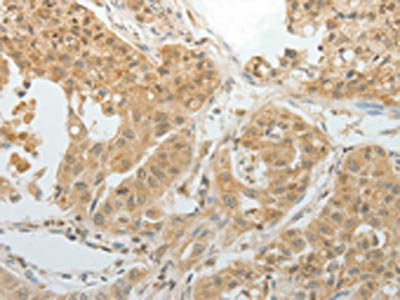

MAP4 Antibody
-
中文名稱(chēng):MAP4兔多克隆抗體
-
貨號(hào):CSB-PA256025
-
規(guī)格:¥1100
-
圖片:
-
The image on the left is immunohistochemistry of paraffin-embedded Human ovarian cancer tissue using CSB-PA256025(MAP4 Antibody) at dilution 1/10, on the right is treated with fusion protein. (Original magnification: ×200)
-
The image on the left is immunohistochemistry of paraffin-embedded Human lung cancer tissue using CSB-PA256025(MAP4 Antibody) at dilution 1/10, on the right is treated with fusion protein. (Original magnification: ×200)
-
-
其他:
產(chǎn)品詳情
-
Uniprot No.:
-
基因名:MAP4
-
別名:DKFZp779A1753 antibody; MAP-4 antibody; MAP4 antibody; MAP4_HUMAN antibody; MGC8617 antibody; Microtubule associated protein 4 antibody; Microtubule-associated protein 4 antibody; OTTHUMP00000210723 antibody; OTTHUMP00000210725 antibody; OTTHUMP00000210727 antibody; OTTHUMP00000210730 antibody
-
宿主:Rabbit
-
反應(yīng)種屬:Human
-
免疫原:Fusion protein of Human MAP4
-
免疫原種屬:Homo sapiens (Human)
-
標(biāo)記方式:Non-conjugated
-
抗體亞型:IgG
-
純化方式:Antigen affinity purification
-
濃度:It differs from different batches. Please contact us to confirm it.
-
保存緩沖液:-20°C, pH7.4 PBS, 0.05% NaN3, 40% Glycerol
-
產(chǎn)品提供形式:Liquid
-
應(yīng)用范圍:ELISA,IHC
-
推薦稀釋比:
Application Recommended Dilution ELISA 1:1000-1:2000 IHC 1:15-1:50 -
Protocols:
-
儲(chǔ)存條件:Upon receipt, store at -20°C or -80°C. Avoid repeated freeze.
-
貨期:Basically, we can dispatch the products out in 1-3 working days after receiving your orders. Delivery time maybe differs from different purchasing way or location, please kindly consult your local distributors for specific delivery time.
-
用途:For Research Use Only. Not for use in diagnostic or therapeutic procedures.
相關(guān)產(chǎn)品
靶點(diǎn)詳情
-
功能:Non-neuronal microtubule-associated protein. Promotes microtubule assembly.
-
基因功能參考文獻(xiàn):
- Expression level of MAP4 mRNA and protein in lung adenocarcinoma tissues were significantly higher than those in noncancerous tissues. MAP4 expression significantly correlated with tumor progression. PMID: 29743960
- Microtubule-associated protein 4 (MAP4) controls the dynein-dependent transport of BTN3A1 in response to nucleic acid stimulation, thereby identifying MAP4 as an upstream regulator of BTN3A1. Thus, the depletion of either MAP4 or BTN3A1 impairs cytosolic DNA- or RNA-mediated type I IFN responses. PMID: 27911820
- an intratumoral injection of MAP4-small interfering RNA (siRNA) remarkably inhibited the growth of the tumors that formed by the MAP4-expressing ESCC cells in nude mice, and a combination of MAP4-siRNA and Bevacizumab significantly enhanced the inhibition effect. Our data suggest that MAP4 is probably a useful prognostic biomarker and a potential therapeutic target for the disease. PMID: 26876215
- MAP4 acts as a checkpoint molecule that balances positive and negative hallmarks of T cell activation. PMID: 28209780
- Results show that marker rs218966 in gene PHF14 and rs9836027 in MAP4 significantly associated with hypertension; additionally, rare variants in SNUPN significantly associated with systolic blood pressure. PMID: 26866982
- We demonstrated that the MAP4 (Ser696 and Ser787) phosphorylation increased concomitantly with the p38/MAPK pathway activation by the LPS and TNF-alpha stimulation of HPMECs, which induced MT disassembly followed by hyperpermeability. PMID: 25746230
- Results demonstrated that MAP4 mutations contribute to the clinical spectrum of centrosomal defects and confirmed the complex role of a centrosomal protein in centrosomal, ciliary, and Golgi regulation associated with severe short stature. PMID: 25323976
- Data show that cAMP/alpha isoform of the catalytic subunit of human PKA (PKAc-alpha) signaling can disrupt microtubule (MT) cytoskeleton by the phosphorylation of microtubule-Associated Protein 4 (MAP4). PMID: 24140250
- MAP4, which is a binding partner of SEPT2. PMID: 23572511
- there are two possible mechanisms triggered by MAP4: stabilization of MT networks; DYNLT1 modulation, which is connected with VDAC1, and inhibition of hypoxia-induced mitochondrial permeabilization PMID: 22164227
- DNAL1 and MAP4 may exert their functions in the HIV life cycle at reverse transcription, prior to nuclear translocation. PMID: 22018492
- Data show that the tau-related protein MAP4 and the microtubule rescue factor CLASP1 are essential for maintaining spindle position and the correct cell-division axis. PMID: 21822276
- Results suggest that structural features of the PJ domain of MAP4 may contribute to the formation of a radial array of microtubules in proliferating cells. PMID: 12079337
- demonstrate that ectopic MAP4 promotes outgrowth of extended MTs during beta1-integrin-induced cell spreading PMID: 12123579
- activity of MAP4 is downregulated by reduced free tubulin concentrations PMID: 12890753
- adenovirus 2 E1B-55K protein blocks p53 as a transcriptional repressor protein of the survivin and the MAP4 promoters PMID: 14527689
- MAP4 microtubule decoration interferes with beta-adrenergic receptor recycling and that this may be one mechanism for beta-adrenergic receptor downregulation in heart failure. PMID: 15528234
- Truncation of the projection domain of MAP4 leads to attenuation of microtubule dynamic instability. PMID: 15840946
- mAP4 interaction with septins modulates microtubule dynamics. PMID: 16093351
- This first report of a genetic alteration involving MAP4 points to a potentially relevant target gene in diffuse large B-cell lymphoma. PMID: 16804917
顯示更多
收起更多
-
亞細(xì)胞定位:Cytoplasm, cytoskeleton.
-
數(shù)據(jù)庫(kù)鏈接:
Most popular with customers
-
-
YWHAB Recombinant Monoclonal Antibody
Applications: ELISA, WB, IHC, IF, FC
Species Reactivity: Human, Mouse, Rat
-
Phospho-YAP1 (S127) Recombinant Monoclonal Antibody
Applications: ELISA, WB, IHC
Species Reactivity: Human
-
-
-
-
-